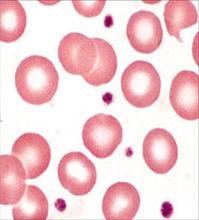
尿紅細胞

疾病指標
尿紅細胞
尿紅細胞 因此肉眼血尿比鏡下血尿出血要多,更加嚴重。正常範圍:每高倍視野10時,尿潛血會體現出陽性(+)。臨床意義:常見的血尿原因有急性腎小球腎炎、慢性腎炎、急性腎盂腎炎、泌尿繫結石。結核、腫瘤、外傷等。如單純出現大量血尿則結石的可能性最大。
病理原因
紅細胞,即尿液中出現的紅細胞。尿紅細胞增多是泌尿系統(腎臟,膀胱或輸尿管)出血,血液進入尿液導致。這種尿標本也被稱作血尿,分為肉眼血尿和顯微鏡下血尿。肉眼血尿即肉眼就可以看出為血色的尿液。當每高倍視野>3個時,但尿外觀並無血色,稱為顯微鏡下血尿。

